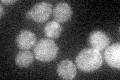
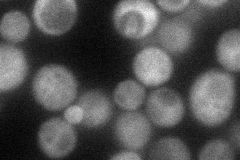
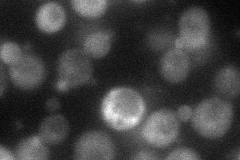
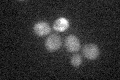

View description
Component of the RAM signaling network that is involved in regulation of Ace2p activity and cellular morphogenesis, interacts with protein kinase Cbk1p and also with Kic1p
Localization:
Intensity:
Fold change:
Significance:
-
C’ GFP library in SD
cytosol20.7 -
N' NOP1pr-GFP in SD
cytosol,bud67.1816 -
N' TEF2pr-mCherry in SD
cytosol38.4893 -
N' NATIVEpr-GFP in SD

cytosol30.7091 -
N' TEF2pr-VC and Cyto-VN in SD

cytosol47.2513 -
C’ GFP library in SD+DTT

cytosol21.351.03No -
C’ GFP library in SD+H2O2

cytosol22.871.1No -
C’ GFP library in Starvation Media
cytosol22.521.08No -
C’ GFP library on the background of Pup2-DaMP

cytosol -
C’ GFP library on the background of CCT mutant

cytosol24.35431.17586No
